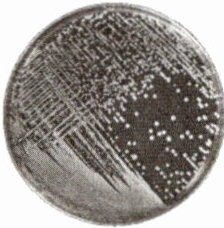

2025年金版学案同步优学智慧作业七年级生物上册苏教版
注:目前有些书本章节名称可能整理的还不是很完善,但都是按照顺序排列的,请同学们按照顺序仔细查找。练习册 2025年金版学案同步优学智慧作业七年级生物上册苏教版 答案主要是用来给同学们做完题方便对答案用的,请勿直接抄袭。
第86页
- 第1页
- 第2页
- 第3页
- 第4页
- 第5页
- 第6页
- 第7页
- 第8页
- 第9页
- 第10页
- 第11页
- 第12页
- 第13页
- 第14页
- 第15页
- 第16页
- 第17页
- 第18页
- 第19页
- 第20页
- 第21页
- 第22页
- 第23页
- 第24页
- 第25页
- 第26页
- 第27页
- 第28页
- 第29页
- 第30页
- 第31页
- 第32页
- 第33页
- 第34页
- 第35页
- 第36页
- 第37页
- 第38页
- 第39页
- 第40页
- 第41页
- 第42页
- 第43页
- 第44页
- 第45页
- 第46页
- 第47页
- 第48页
- 第49页
- 第50页
- 第51页
- 第52页
- 第53页
- 第54页
- 第55页
- 第56页
- 第57页
- 第58页
- 第59页
- 第60页
- 第61页
- 第62页
- 第63页
- 第64页
- 第65页
- 第66页
- 第67页
- 第68页
- 第69页
- 第70页
- 第71页
- 第72页
- 第73页
- 第74页
- 第75页
- 第76页
- 第77页
- 第78页
- 第79页
- 第80页
- 第81页
- 第82页
- 第83页
- 第84页
- 第85页
- 第86页
- 第87页
- 第88页
- 第89页
- 第90页
- 第91页
- 第92页
[例]下图为各种微生物结构示意图,相关描述正确的是 ( )

A.①的细胞结构简单,由蛋白质外壳和内部的遗传物质组成
B.和植物细胞相比,②中没有细胞壁
C.②和③的细胞结构是最相似的,都有成形的细胞核
D.③④⑤都属于真菌
答案:
B
培养并观察细菌菌落
【目标】培养并观察细菌菌落特征。
【器材】培养箱,培养皿,放大镜,已高温灭菌的牛肉膏蛋白胨固体培养基等。
【步骤】
1. 分小组取制备好的牛肉膏蛋白胨固体培养基,打开培养皿皿盖,用手指轻轻按压培养基,再盖上皿盖,将培养皿倒置放入培养箱,
2. 从培养箱中取出培养皿,查看培养结果,注意观察菌落特征(大小、形状、颜色等)。如右下图,细菌菌落特征是菌落比较

3. 设计并填写观察记录表。依据记录,总结细菌的菌落特征。
4. 观察结束后,要对培养基作无害化处理。
【目标】培养并观察细菌菌落特征。
【器材】培养箱,培养皿,放大镜,已高温灭菌的牛肉膏蛋白胨固体培养基等。
【步骤】
1. 分小组取制备好的牛肉膏蛋白胨固体培养基,打开培养皿皿盖,用手指轻轻按压培养基,再盖上皿盖,将培养皿倒置放入培养箱,
37
℃下培养24~48 h。2. 从培养箱中取出培养皿,查看培养结果,注意观察菌落特征(大小、形状、颜色等)。如右下图,细菌菌落特征是菌落比较
小
(填“大”或“小”),表面或光滑黏稠,或粗糙干燥,颜色可呈白
、黄、红等多种颜色。
3. 设计并填写观察记录表。依据记录,总结细菌的菌落特征。
4. 观察结束后,要对培养基作无害化处理。
答案:
【步骤】1.37 2.小 白
查看更多完整答案,请扫码查看


